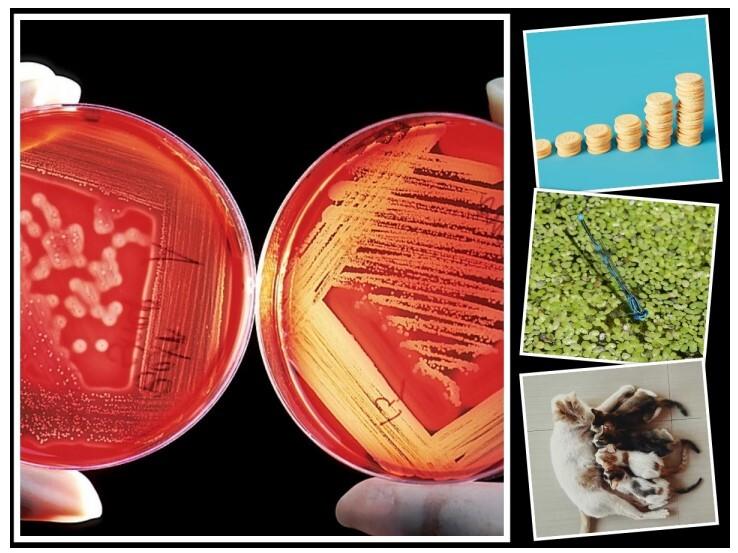

Klasse 10
Zur Bestimmung von Nullstellen quadratischer Funktionen lernen die Schüler:innen wichtige Lösungsverfahren wie die quadratische Ergänzung und die pq-Formel kennen und anwenden. Auch in der 10. Klasse sind die Funktionen von Bedeutung. Hier geht es im Besonderen um das exponentielle Wachstum, das mit Hilfe mathematischer Verfahren in vielfältigen Alltagssituationen untersucht wird. Außerdem lernen die Schüler:innen die trigonometrischen Funktionen kennen (Sinus, Kosinus und Tangens).
Inhalte Klasse 10